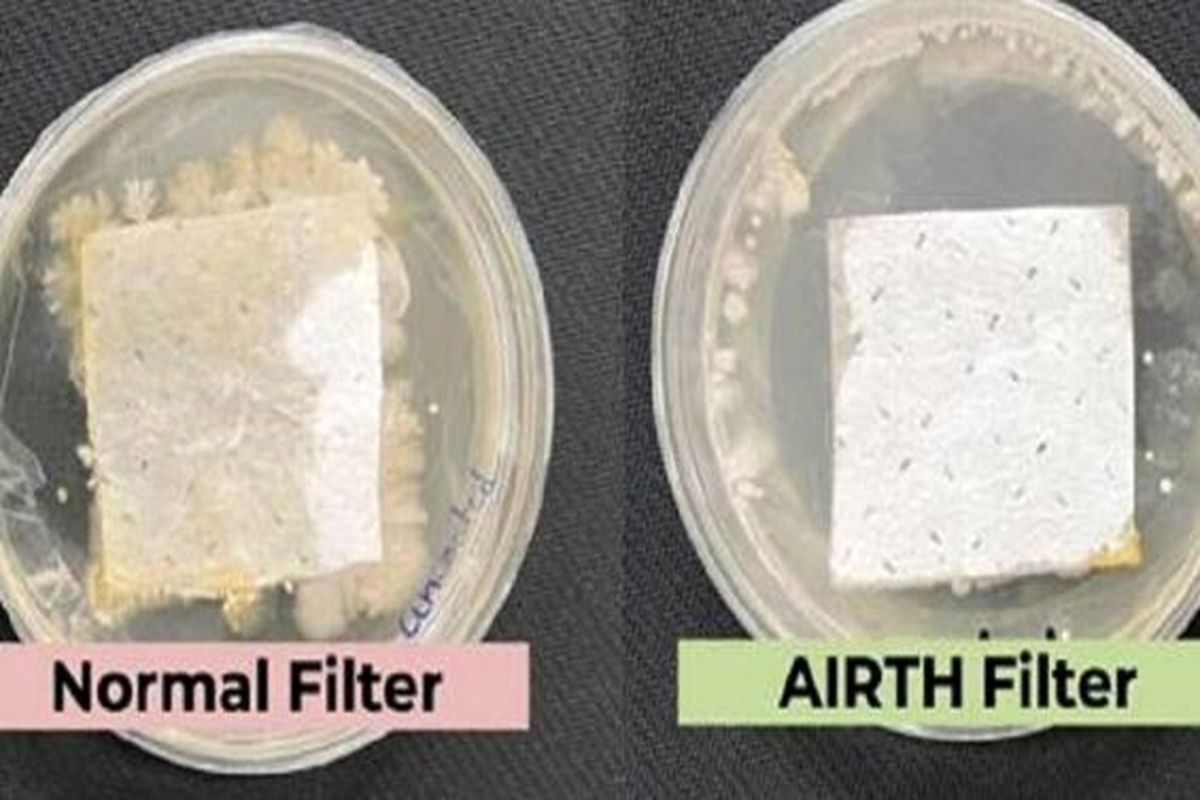
ابداع فیلترهای جدید تصفیه هوا از آنزیم‌های گیاهی

برچسب - علم و فناوری
یادداشت؛ محمد همت - دبیر ستاد آب، اقلیم و محیط زیست معاونت علمی، فناوری و اقتصاد دانش بنیان ریاست جمهوری
کد خبر: ۱۴۸۹۳۸۶
۱۴۰۲/۰۴/۰۱
سرپرست دانشگاه پیام نور گفت: دانشگاه پیام نور در راستای درآمدزایی غیرشهریه ای و همچنین ارتباط بیشتر بین دانشگاه با جامعه و صنعت، پردیس مشترک بین پیام نور استان با پارک علم و فناوری امیرکبیر را بستر مناسبی برای استفاده از ظرفیت های موجود دو دانشگاه معرفی نمود..
کد خبر: ۱۴۸۷۶۸۶
۱۴۰۲/۰۳/۲۸
رویداد تخصصی جلوههای بصری سینمای ایران 5 تیرماه جاری به همت بنیاد سینمایی فارابی و با مشارکت ستاد توسعه فناوریهای فرهنگی و نرم برگزار میشود.
کد خبر: ۱۴۸۶۹۹۵
۱۴۰۲/۰۳/۲۷
طرح های توسعهای و دانشی رصدخانه ملی ایران با حضور رییس پژوهشگاه دانشهای بنیادی و معاون علمی، فناوری و اقتصاد دانشبنیان رییسجمهوری مطرح شد و مورد بررسی قرار گرفت.
کد خبر: ۱۴۸۶۹۸۹
۱۴۰۲/۰۳/۲۷
رئیس جهاددانشگاهی فارس با بیان اینکه این نهاد با احصای نیازهای علمی جامعه پروژههای دانشبنیان برای خود تعریف کرده و آنها را به سرانجام میرساند، گفت: جهاددانشگاهی دارای ابعاد مختلف علمی، پژوهشی، فرهنگی، اجتماعی و... است که برای توسعه کشور نیاز است از تمام ظرفیتهای جهاددانشگاهی در تمام نقاط کشور استفاده بهینه شود.
کد خبر: ۱۴۸۶۹۸۵
۱۴۰۲/۰۳/۲۷
نشست هماندیشی جمعی از نخبگان و صاحبان استعدادبرتر با وزیر آموزشوپرورش و قائم مقام بنیاد ملی نخبگان برگزار شد.
کد خبر: ۱۴۸۶۹۰۷
۱۴۰۲/۰۳/۲۷
یک استارتاپ ژاپنی، طرح جاهطلبانهای را برای احداث یک شهر شناور در آینده ارائه داده است که میتواند تا ۴۰ هزار نفر را در خود جای دهد و امکانات مورد نیاز ساکنان را تامین کند.
کد خبر: ۱۴۸۶۷۷۷
۱۴۰۲/۰۳/۲۷
عقرب دریایی که رسما Pterygotus australis نامیده می شود، در طول دوره سیلورین در آب های استرالیا باستان پرسه می زد. با اندازه چشمگیر و ظاهر مهیب خود، بدون شک یکی از شکارچیان برتر زمان خود بود. یافتن چنین نمونه ای که به خوبی حفظ شده است، بینش ارزشمندی را در مورد اکولوژی و تکامل حیات دریایی در این دوره ارائه می دهد.
کد خبر: ۱۴۸۶۷۷۶
۱۴۰۲/۰۳/۲۷
رئیس مرکز توسعه هوش مصنوعی در پژوهشگاه ارتباطات و فناوری اطلاعات گفت: در تعامل با وزارت بهداشت تلاش میکنیم بیمارستان هوشمند به صورت کامل برای خدمات رسانی به مردم افتتاح شود.
کد خبر: ۱۴۸۶۷۶۹
۱۴۰۲/۰۳/۲۷
چنین ابرنواختری از نظر قریب الوقوع بسیار نادر به نظر و احتمال آن وجود دارد که صرفا یکبار در هر میلیارد سال رخ دهد.
کد خبر: ۱۴۸۶۷۶۷
۱۴۰۲/۰۳/۲۶
یک آرشیو جدید نقشهی مریخ کل سیارهی سرخ را در کف دست شما قرار میدهد و اکنون هر کسی روی کرهی زمین با یک گوشی هوشمند میتواند این دادهها را جستجو و استفاده کند و شگفت زده شود.
کد خبر: ۱۴۸۶۷۶۱
۱۴۰۲/۰۳/۲۶
شرکت چند ملیتی خدمات و مشاوره «Accenture» در گزارشی اعلام کرد که شرکتهای چینی پیشرفت در زمینه هوش مصنوعی مولد را حیاتی میدانند، زیرا این فناوری و سایر فناوریهای در حال تکامل، آیندهای را برای کسبوکارها رقم میزنند که در آن دنیای فیزیکی و دیجیتال عمیقاً با هم مرتبط هستند.
کد خبر: ۱۴۸۶۷۵۴
۱۴۰۲/۰۳/۲۶
محققان مؤسسه علوم هند، یک فیلتر هوای ضد میکروبی تولید کردهاند که میتواند میکروبهای جمعشده را غیرفعال و هوای محیط را تصفیه کند.
کد خبر: ۱۴۸۶۷۵۲
۱۴۰۲/۰۳/۲۶
مقامات استکهلم در نظر دارند بهزودی، یک کشتی مسافربری تجاری خودران و تمام الکتریکی را در این شهر راهاندازی کنند.
کد خبر: ۱۴۸۶۷۵۰
۱۴۰۲/۰۳/۲۶
آمازون با تصریح استفاده از یادگیری ماشینی برای سرکوب نقدهای جعلی از دولتها خواست در این راستا همکاری بیشتری داشته باشند.
کد خبر: ۱۴۸۶۷۴۷
۱۴۰۲/۰۳/۲۶
گروهی فراحزبی متشکل از شش سناتور و دو عضو مجلس نمایندگان ایالاتمتحده آمریکا، مدعی هستند که لایحهای را برای محافظت از دادههای آمریکاییها در برابر استفاده دشمنان این کشور ارائه کردهاند.
کد خبر: ۱۴۸۶۷۰۳
۱۴۰۲/۰۳/۲۶
محققان چینی موفق به ساخت دستگاهی شدهاند که قادر است نشانههای عصبی را به گفتار صوتی تبدیل کند.
کد خبر: ۱۴۸۶۶۸۸
۱۴۰۲/۰۳/۲۶
رئیس مرکز رشد پژوهشگاه نیرو با تأکید بر آمادگی این مرکز برای جذب شرکتهای توانمند از سراسر کشور از پیگیری برای افزایش ۱۰۰ درصدی شرکتهای فناور عضو خبر داد.
کد خبر: ۱۴۸۶۶۶۰
۱۴۰۲/۰۳/۲۶
ناسا قصد دارد از یک ربات تغییر شکلپذیر برای انجام طیف گستردهای از وظایف کمک بگیرد.
کد خبر: ۱۴۸۶۶۴۷
۱۴۰۲/۰۳/۲۶
نخستین نمایشگاه فناوری ها و محصولات محرومیت زدا (آبادیران)، عصر پنجشنبه با معرفی و تقدیر از برترین طرحهای دانش بنیان محرومیتزدا و غرفههای برتر از لحاظ تفاهمنامههای منعقد شده خاتمه یافت.
کد خبر: ۱۴۸۶۶۴۵
۱۴۰۲/۰۳/۲۶